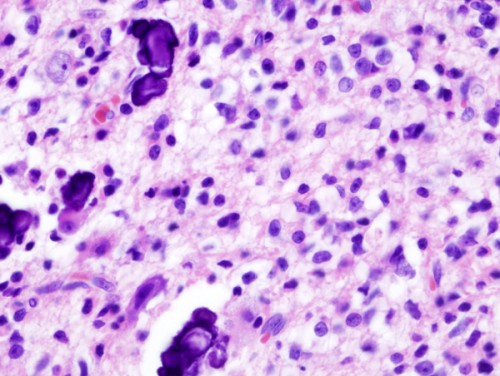

Escozul
Escozul: la Labiofam non riesce a far fronte alle migliaia di richieste

L’ambasciata italiana di Cuba ha fatto sapere tramite un comunicato stampa che la Labiofam non è attualmente in grado di far fronte alle migliaia di richieste di Escozul, in quanto la produzione al momento è limitata poichè si tratta di una sostanza di origine animale che necessita di un ciclo di produzione che non può essere forzato, viste le regole stabilite per la protezione della specie.
Nonostante la Labiofam abbia incrementato la produzione, la richiesta è troppo vasta per poter accontentare tutti, anche perchè no si tratta di un qualcosa che si possa ottenere in un lasso di tempo breve anche perchè si tratta di un farmaco ancora in fase di sperimentazione e quindi non ancora producibile su larga scala.
Nonostante la Labiofam abbia incrementato la produzione, la richiesta è troppo vasta per poter accontentare tutti, anche perchè no si tratta di un qualcosa che si possa ottenere in un lasso di tempo breve anche perchè si tratta di un farmaco ancora in fase di sperimentazione e quindi non ancora producibile su larga scala.
Aumentano i farmaci contraffatti su internet

Abbiamo già parlato di quanto possa essere rischioso comprare farmaci su internet proprio perchè il rischio è quello di imbattersi in farmaci contraffatti e molte volte vengono scoperte delle truffe,in cui vengono spacciati farmaci falsi per autentici.
Ad esempio è il caso dell’ Escozul, il veleno di scorpione azzurro di Cuba che viene dato gratuitamente a tutti coloro che si recano sull’isola a prenderlo, portando con sè le cartelle cliniche, ma che alcune persone senza scrupoli lo vendono su internet a prezzi esosi speculando sul dolore e sulla speranza della gente che soffre.
Ad esempio è il caso dell’ Escozul, il veleno di scorpione azzurro di Cuba che viene dato gratuitamente a tutti coloro che si recano sull’isola a prenderlo, portando con sè le cartelle cliniche, ma che alcune persone senza scrupoli lo vendono su internet a prezzi esosi speculando sul dolore e sulla speranza della gente che soffre.
Amaro Svedese e i suoi utilizzi

Come l’Escozul e l’Essiac che sembra possano curare il cancro, anche l’amaro svedese ha molte proprietà curative.
L’amaro svedese è un prodotto naturale dalle mille proprietà che aiuta a curare diverse patologie dalla cervicale al vaiolo.
A seconda della cura che si deve fare, il prodotto si può usare in diversi modi: lo si può inalare per curare la cervicale o per le affezioni delle vie respiratorie ad esempio, lo si assume invece per via orale per i disturbi gastro- intestinali, oppure può essere utilizzato anche come impacco per dolori o strappi muscolari.
L’amaro svedese è un prodotto naturale dalle mille proprietà che aiuta a curare diverse patologie dalla cervicale al vaiolo.
A seconda della cura che si deve fare, il prodotto si può usare in diversi modi: lo si può inalare per curare la cervicale o per le affezioni delle vie respiratorie ad esempio, lo si assume invece per via orale per i disturbi gastro- intestinali, oppure può essere utilizzato anche come impacco per dolori o strappi muscolari.
Essiac, che cos’è?

Parlando di Escozul, il veleno dello scorpione azzurro cubano che aiuta a curare il cancro, e delle testimonianze di chi è guarito come Josè Monzon che lo produce privatamente dopo aver curato la figlia, bisogna parlare anche di Essiac.
L’Essiac è una miscela di erbe usata per preparare una tisana che sembra abbia dei poteri anti -tumorali ma ad oggi non esistono delle prove scientifiche in proposito.
Venne inventata da un’infermiera canadese, Rene Caisse che diede il nome a questo preparato invertendo il suo cognome.
Pare però che fosse stato inventato dai nativi Ojibway (una popolazione nomade americana che viveva nel Michigan) e contiene acetosa, scorza interna di olmo viscido, rabarbaro indiano e radici di bardana.
L’Essiac è una miscela di erbe usata per preparare una tisana che sembra abbia dei poteri anti -tumorali ma ad oggi non esistono delle prove scientifiche in proposito.
Venne inventata da un’infermiera canadese, Rene Caisse che diede il nome a questo preparato invertendo il suo cognome.
Pare però che fosse stato inventato dai nativi Ojibway (una popolazione nomade americana che viveva nel Michigan) e contiene acetosa, scorza interna di olmo viscido, rabarbaro indiano e radici di bardana.
Escozul: il direttore della Labiofam dice di fare attenzione a chi lo vuol vendere

Un caso mediatico che ha fatto parlare tutto il mondo e continua a far discutere è l’Escozul, il veleno di scorpione azzurro che, secondo Josè Monzon, guarito lui stesso, dice che può curare il cancro.
Sono così iniziate speculazioni di ogni tipo, tanto da far nascere un gruppo molto numeroso su Facebook di persone che credono che il veleno dello scorpione aiuti a curare il cancro e avvertono di non fidarsi di chi lo vende su internet.
Il problema è che è molto facile imbattersi nelle truffe, soprattutto sul web, di persone che, approfittandosi della sofferenza della gente, si offrono di portare da Cuba il medicinale sotto lauto compenso.
Teniamo a ribadire ancora una volta che il farmaco è gratuito e viene consegnato direttamente dai medici incaricati della Labiofam (l’azienda statale cubana che lo produce su larga scala) a chi si presenta con le cartelle cliniche che dimostrano il tumore.
Sono così iniziate speculazioni di ogni tipo, tanto da far nascere un gruppo molto numeroso su Facebook di persone che credono che il veleno dello scorpione aiuti a curare il cancro e avvertono di non fidarsi di chi lo vende su internet.
Il problema è che è molto facile imbattersi nelle truffe, soprattutto sul web, di persone che, approfittandosi della sofferenza della gente, si offrono di portare da Cuba il medicinale sotto lauto compenso.
Teniamo a ribadire ancora una volta che il farmaco è gratuito e viene consegnato direttamente dai medici incaricati della Labiofam (l’azienda statale cubana che lo produce su larga scala) a chi si presenta con le cartelle cliniche che dimostrano il tumore.
Glutatione, un potente antiossidante

Il glutatione è un forte antiossidante che l’organismo può produrre e ha un’ azione molto rilevante contro i radicali liberi e contro le molecole come il perossido di idrogeno, i benzoati, i nitrati ed i nitriti e può essere assunto per via orale o per via endovenosa come integratore.
Combatte l’invecchiamento delle cellule tramite due vie principali: il sistema circolatorio e l’ intestino, proteggendo le cellule, gli organi e i tessuti mantenendo l’organismo giovane.
Il glutatione è una combinazione di tre amminoacidi ( detto Tripeptide ) che sono la cisteina, l’ acido glutamminico e la glicina ma è quasi sconosciuto alla medicina ufficiale e non viene utilizzato per le sue potenti proprietà.
Combatte l’invecchiamento delle cellule tramite due vie principali: il sistema circolatorio e l’ intestino, proteggendo le cellule, gli organi e i tessuti mantenendo l’organismo giovane.
Il glutatione è una combinazione di tre amminoacidi ( detto Tripeptide ) che sono la cisteina, l’ acido glutamminico e la glicina ma è quasi sconosciuto alla medicina ufficiale e non viene utilizzato per le sue potenti proprietà.